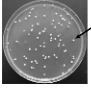
<p>Which plating technique is this? Colonies are evenly distributed across the surface of plate media</p>

1/67
Looks like no tags are added yet.
Name | Mastery | Learn | Test | Matching | Spaced |
|---|
No study sessions yet.
Which technique allowed us to view living microbes as they moved around?
wet mount in bright field, wet mount in dark field, hanging drop technique
During lab, how did you create enough contrast to view living, unstained yeast and bacteria in a hanging drop?
closed the iris diaphragm on the microscope. This adjustment created enough contrast to see yeast cells without any stains
results of stab test with non-motile organism
organism stayed at the stab line
results of stab test with motile organism
organism moved away from stab line and spread throughout the tube
which type of media contains no agar?
broth media
Why is agar added to certain types of microbial media?
to solidify media
obligate aerobes
require oxygen for survival
obligate anaerobes
die in the presence of oxygen
facultative anaerobes
can grow in the presence or absence of oxygen
psychro-
cold in relation to the middle of the range
thermo
hot in relation to the middle of the range
meso
middle
mesophiles
survive in the middle of the temperature range that supports microbial life
halo-
salt / salinity
halotolerant
can grow in a wide range of salt concentrations

the results of an agar deep stab are below. Since this microbe grew along the entire stab line, it is considered a:
facultative anaerobe

Based on the results shown below, Microbe X is an extreme _____. It only grows in high concentrations of sodium chloride (salt)
halophile

As shown in the table, Staphylococcus aureus is _____. This term means S. aureus can grow in a wide range of sodium chloride concentrations
halotolerant
the _____ technique is used to embed bacterial colonies throughout plate media. To perform this technique, liquified agar plate media is swirled together with the test sample.
pour plate
_____ occurs when two organisms work together to do something that neither one can do alone
synergism
_____ occurs when one organism benefits from another organism. (The other organism is not affected in a positive or negative manner)
commensalism
antibiosis means _____
one organisms harms another
during lab, a student _____ a tube of nutrient broth when they accidentally sneezed into it
contaminated
during lab, a student _____ a tube of nutrient broth when they intentionally added Staphylococcus epidermis to it
inoculated
what’s the proper way to sterilize metal inoculation loops and needles during lab
hold the end of the tool in a flame until it glows red. Once it cools down, it is ready for use
what’s the proper way to sterilize a bacterial spreader
dip the end of the tool in ethanol. QUICKLY pass the end of the tool through a flame. By the time the ethanol burns off, the tool is ready for use
which part of a Petri dish should be labeled with your initials and pertinent info about the experiment
bottom/base of plate (the part that holds the agar medium)
which technique is used to inoculate agar slant tubes
zig-zag inoculation
which technique produces a solid layer of bacteria on the surface of plate media? A sterile swab is used to inoculate the plate
lawn plate

which plating technique is this?
streak plate
True or False: drinks and food are allowed in microbiology laboratories
false

as shown: a _____ is a visible clump of bacterial cells. the cells within this structure arose through binary fission, so they are all genetically identical
colony
Which plating technique is this? Colonies are evenly distributed across the surface of plate media
spread plate
To prevent condensation from dripping onto your plate cultures, it’s best to incubate Petri dishes in this position
upside down (lid underneath the agar medium)
before leaving microbiology lab for the day, you should _____
disinfect your work surface
dispose of your nitrile gloves
wash your hands
you’re instructed to spot inoculate E. coli broth culture on two separate plates. How is this accomplished aseptically?
You should always flame the loop (aka sterilize the loop) between inoculations

part labeled 1
ocular lens

part labeled 2
nosepiece

part labeled 3
objective lens

part labeled 4
stage

part labeled 5
light source

part labeled 6
course adjustment knob
immersion oil is only used with the _____ objective lens
100x
which objective lens gets blurry when it’s accidentally dipped into immersion oil? We skip this objective when refocusing oily slides
40x
what is the total magnification of a microscope when the 10x ocular lenses are used in conjunction with the 4x objective lens?
40x
what is the total magnification of a microscope when the 10x ocular lenses are used in conjunction with the 10x objective lens
100x
bacillus
rod-shaped
coccus
spherical/round shape
strepto-
chains
staphylo-
clusters
diplo-
pairs

which shape and arrangement is this bacteria?
staphylococcus

which shape and arrangement is this bacteria?
streptobacilli

what shape and arrangement is this bacteria?
streptococcus

what shape and arrangement is this bacteria?
diplococci
What is the purpose of heat-fixing certain bacterial smears
heat dehydrates cells and helps them adhere to glass slides

which plating technique is this? Liquefied agar medium is swirled together with a specific volume of the test sample. Following incubation, colonies are embedded throughout the plate medium
pour plate
following the Gram stain procedure, Gram-negative bacteria are _____ in color
pink
following the Gram stain procedure, Gram-positive bacteria are _____ in color
purple
why is 10 minutes of steaming required for certain staining techniques
steam drives stains into hard-to-stain structures, such as spores and the waxy cell walls of acid-fast bacteria
Which tool is used to stab inoculate motility media
metal inoculation needle
two methods we used to test oxygen requirements of different microbes
agar deep stab and anaerobic jar
we observed antibiosis in lab when:
Bacillus subtilis secreted the antibiotic bacitracin. This inhibited growth of Micrococcus luteus, a yellow Gram positive bacterial species
we observed synergism in lab when:
the WF (white) and OF (orange) mutant strains of Serratia marcescens worked together to make a red pigment (prodigiosin) that neither can make alone
we observed commensalism in lab when:
Clostridium (an obligate anaerobe) was able to grow in an aerobic environment when Staphylococcus epidermis was present
antiseptics
reduce the number of microbes on living tissues
disinfectants
reduce the number of microbes on inanimate surfaces
proper way to sterilize forceps in lab
dip the end of the tool in ethanol. QUICKLY pass the end of the tool through a flame. By the time the ethanol burns off, the tool is ready for use.